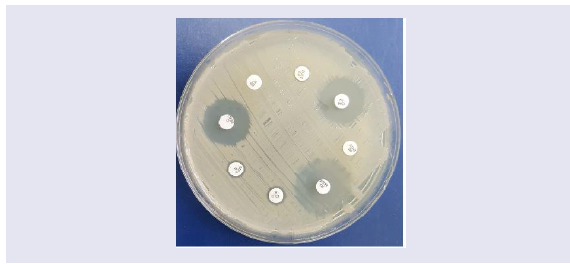

Journal of Clinical & Medical Case Reports
Download PDF
Review Article
Emerging Antibiotic Resistance in Post-COVID-19 Co-infections
Sibi Das1*, Sethi Das C2, Jibin VG3 and Silvanose CD4
1Sri Siddhartha Medical College, Tumkuru, Karnataka, India
2Aster CMI Hospital, Bengaluru, India
3District Hospital, Bundi, Rajasthan, India
4Dubai Falcon Hospital, Dubai, UAE
Address for Correspondence:
Das S, Sri Siddhartha Medical College, Tumkuru, Karnataka,
India; E-mail: sdsilvanose@gmail.com
Submission: 22 February, 2023
Accepted: 23 March, 2023
Published: 28 March, 2023
Copyright: © 2023 Sibi D, et al. This is an open access article
distributed under the Creative Commons Attribution License,
which permits unrestricted use, distribution, and reproduction
in any medium, provided the original work is properly cited.
Abstract
There is emerging evidence of antibiotic resistance, particularly
for antibiotics commonly used to treat secondary bacterial infections
in COVID-19 patients. The overuse of antibiotics in COVID-19 patients
has contributed to the development of antibiotic-resistant bacterial
strains against amoxicillin, azithromycin, cephalosporins, ciprofloxacin,
and carbapenem. The most resistant bacteria isolated from COVID-19
patients include Klebsiella pneumonia, Acinetobacter baumannii,
and Pseudomonas aeruginosa, which showed multiple antibiotic
resistance. The increasing rates of antibiotic resistance are labeled as
a “silent pandemic” as post covid-19 bacterial infections caused by
deadly pathogens are the most significant threats to global health.
Keywords
Antibiotic Resistance; Post-COVID-19 infections; Bacterial
Pneumonia
Introduction
Antibiotics have been extensively used to treat secondary bacterial
infections and as a preventative measure in COVID-19 patients.
However, the widespread use of antibiotics, particularly prophylaxis
use, has contributed to the emergence of new, antibiotic-resistant
bacterial strains, posing a threat to post-COVID-19 patients with
weakened immune systems [1-4]. Studies have shown that patients
with severe COVID-19 symptoms are more prone to developing
secondary bacterial infections. The overuse and misuse of antibiotics
in COVID-19 patients have also contributed to the development and
spread of antibiotic-resistant bacteria. It raises concerns about the
potential emergence of antibiotic-resistant bacteria that could further
complicate the treatment of COVID-19 patients and other infections.
Antibiotic resistance occurs when bacteria evolve to resist the effects
of antibiotics, making it more challenging to treat infections. This
review article will explore the potential impact of the COVID-19
pandemic on antibiotic resistance and discuss the strategies to
mitigate this emerging threat.
Post-COVID-19 Bacterial Pneumonia:
The COVID-19 pandemic can lead to the development of
bacterial pneumonia in individuals. Due to a weakened immune
system, a person with COVID-19 is more vulnerable to developing
a secondary bacterial infection in their lungs. The bacteria
associated with COVID-19 pneumonia with bacterial co-infection
include Mycoplasma pneumonia, Streptococcus pneumoniae,
Staphylococcus aureus, Klebsiella pneumonia, Acinetobacter
baumannii, Pseudomonas aeruginosa [3-6]. The most isolated
bacteria in COVID-19 patients were Streptococcus pneumoniae
while Acinetobacter baumannii, Pseudomonas aeruginosa, Klebsiella pneumonia, and Staphylococcus aureus were isolated in those who
require hospitalization or ventilator support [2-5].Post-COVID-19 bacterial pneumonia is a potential complication that may arise after a person has recovered from COVID-19.
COVID-19 weakens the immune system, which could make a
person more susceptible to secondary bacterial infections, including
pneumonia. Symptoms of bacterial pneumonia include cough,
fever, chest pain, shortness of breath, fatigue, and in severe cases,
coughing up blood [3-5]. If a person develops bacterial pneumonia
after recovering from COVID-19, they may require antibiotics to
treat the infection. Treatment may also involve oxygen therapy,
bronchodilators, and other supportive measures to help with
breathing and other symptoms [7,8].
Secondary bacterial infections and co-infections can occur
in individuals already infected with a virus, such as influenza or
COVID-19. This type of infection can be more severe and difficult
to treat than infections caused by a single pathogen. A secondary
bacterial infection could occur when bacteria infect an individual
already infected with a virus or another pathogen. It can occur
because the virus weakens the immune system, making it easier for
bacteria to cause an infection. In severe cases, the virus may also
damage the respiratory tract, making it easier for bacteria to infect
the lungs. A global study from 204 countries and territories found
that 13.6% of all global deaths were associated with 33 pathogens,
and over 50% of deaths were caused by five pathogens, including
Staphylococcus aureus, Escherichia coli, Streptococcus pneumoniae,
Klebsiella pneumonia, and Pseudomonas aeruginosa [9].
Pneumonia caused by Mycoplasma pneumonia:
Mycoplasma pneumonia is a type of bacteria without a cell wall that
can cause pneumonia and bronchitis, and it was one of the common
co-infections found in patients with COVID-19. Beta-Lactam, such as
Amoxycillin and cephalosporins are ineffective against Mycoplasma
pneumoniae as these antibiotics target to block bacterial cell wall
biosynthesis. Azithromycin and clarithromycin are the antibiotics
used to treat Mycoplasma infections as it works by inhibiting
bacterial protein synthesis [7-11]. They bind to the 50S subunit of
bacterial ribosomes, preventing the elongation of nascent peptides and inhibiting the translation of bacterial proteins. Fluoroquinolones
such as ciprofloxacin, moxifloxacin, levofloxacin, and ofloxacin are
another option for Mycoplasma treatment as they interface with
bacterial DNA replication and transcription [7-11].The symptoms of Mycoplasma pneumonia include a nonproductive
cough, sore throat, headache, fatigue and weakness, fever
and chills, chest pain, and shortness of breath or breathing difficulty.
Diagnosis includes a physical exam, chest X-ray or CT scan, blood
tests for Mycoplasma antibodies, and PCR testing for Mycoplasma
pneumoniae in respiratory secretions. Pneumonia caused by
Mycoplasma could be diagnose with its symptoms, diagnostic
tests, and response to treatment. Typical bacteria like Streptococcus
pneumonia and Acinetobacter baumannii pneumonia are typically
associated with a productive cough and more severe symptoms.
Mycoplasma pneumonia is associated with a non-productive cough
and milder symptoms [6,8]. Additionally, Mycoplasma pneumonia
can often be diagnosed with blood tests or PCR testing for the
presence of the bacteria.
Pneumonia caused by Gram-positive Bacteria (Streptococcus pneumonia & Staphylococcus aureus):
Streptococcus pneumoniae is a common cause of bacterial
pneumonia in COVID-19 patients, and some antibiotics commonly
used for the treatment include Penicillin, Cephalosporins, and
Macrolides [10]. The bacterial pneumonia symptoms are high
fever, chest pain, and cough, which may produce phlegm or phlegm
with blood, shortness of breath or breathing difficulty, fatigue and
weakness, rapid heartbeat, confusion, or disorientation, especially in
elderly or immune compromised patients. Diagnosis of Streptococcus
pneumoniae infection includes a physical exam, chest X-ray or CT
scan, rapid strep antigen test in throat swab, sputum culture, and
sensitivity testing [4,7,8].Staphylococcus aureus was isolated from hospitalized
COVID-19 patients with co-infections of bacterial pneumonia,
including methicillin-susceptible and resistant strains. Amoxycillin/
clavulanate, cephalosporins, and Macrolides are the antibiotics
treated in methicillin-susceptible bacterial strains. While,
Vancomycin, linezolid, daptomycin, or cefazoline have been used to
treat methicillin-resistant Staphylococcus aureus [12].
Pneumonia caused by Gram-negative Bacteria (A. baumannii, P. aeruginosa, E. coli, and K. pneumonia):
Gram-negative organisms predominantly isolated from
COVID-19 cases that cause co-infections were Acinetobacter
baumannii, Pseudomonas aeruginosa, Escherichia coliand Klebsiella pneumonia [12-14]. Pneumonia caused by typical bacteria can
confirm by sputum culture and sensitivity testing (Figure 1).
Figure 1: The culture appearance of Klebsiella pneumonia on MacConkey’s
agar shows mucoid, lactose fermenting pink colonies.
B-Lactams including Amoxycillin, Amoxicillin-clavulanic
acid, 2nd-generation cephalosporins such as Cefaclor, Cefuroxime
and 3rd-generation cephalosporins such as Cefixime, Cefotaxime,
Cefpodoxime, Ceftazidime, and Ceftizoxime used to treat as it
prevents bacterial cell wall biosynthesis [12-14]. The choice of
antibiotic will depend on the specific type of bacteria causing the
infection and its susceptibility to different antibiotics (Figure 2).
Figure 2: Antibiotic sensitivity of Klebsiella pneumonia showing resistance
to Ciprofloxacin (CIP), Moxifloxacin (MFX), Amoxycillin (A), Amoxycillin/
Clavulanate (AUG), and Doxycycline (DXT). Gentamycin (GM) and
Cefuroxime (CFM) show a zone of inhibition of bacterial growth (Sensitive),
while Azithromycin (ATH) shows secondary growth in the primary inhibited
zone.
The symptoms of Acinetobacter baumannii pneumonia can vary but are typically similar to other bacterial pneumonia that produces
phlegm or phlegm with blood. The diagnosis included a physical
exam, chest X-ray or CT scan, and collection of a sputum sample for
culture and sensitivity testing. Pneumonia caused by Acinetobacter
baumannii could be a severe problem due to its ability to develop
resistance to multiple antibiotics, making it difficult to treat.
Pneumonia caused by Acinetobacter baumannii has been treated with
antibiotics belonging to carbapenems such as Imipenem, Meropenem,
Ertapenem, and Doripenem [12-19]. It may involve a combination
of antibiotics in a hospital setting to monitor the patient’s condition
and provide supportive care. Empiric antibiotic therapy was initiated
while waiting for the confirmation of antibiotic sensitivity. The
symptoms of pneumonia caused by Gram-negative bacteria were
similar to other bacterial infections. Table 1 summarizes the common
antibiotics used in COVID-19 patients with co-infections of bacterial
pneumonia [20].
Table 1: Most used antibiotics to treat co-bacterial infections and secondary bacterial infections in association with COVID-19. (Sibi Das et al, Genesis Journal of
Medicine and surgery 2023).
Global overview of Antibiotic use in COVID-19 patients:
Antibiotic therapy was given to COVID-19 patients as prophylaxis
to prevent secondary infections in moderate or severe COVID-19
patients or treat co infections and secondary infections caused
by bacteria. A review study focused on China found that 74% of
hospitalized COVID-19 patients had antibiotic treatment, and 36.9%
had treatment with Glucocorticoids [12,14,16,18]. Fluoroquinolones
were most used in 56.8% of patients, followed by Ceftriaxone in
39.5% of patients, then azithromycin in 29.1% of patients [12,14].
This treatment included 7.6% of confirmed bacterial coinfection and
secondary infections, mainly bacterial pneumonia, bacteremia, and other coinfection caused by Acinetobacter baumannii, Staphylococcus
species, Pseudomonas aeruginosa and Klebsiella pneumonia
[12,14,16,18]. Antibiotics were used in severe COVID-19 patients
to prevent secondary infection as the COVID-19 virus weakens
the immune system. Many studies from China reported the use of
antibiotics in severe COVID-19 patients was 80% to 100%, and in
non-severe patients was 45% to 54%, while other studies from China
report 75.4% of patients received empiric antibiotics despite severe
disease. All these studies reported higher antibiotic use in COVID-19
patients [12,14,16,18].Antibiotics were prescribed to 75% of COVID-19 patients, while
confirmed bacterial co infection rates are less than 10%. On the
above background, a meta-study of Global antibiotic use during the
COVID-19 pandemic analyzed through the pharmaceutical sales
data from 71 countries found a monthly 10% increase in antibiotic
use-associated cases across continents including Africa, Asia, Europe,
North America, and South America, which includes Cephalosporins,
Macrolides, Penicillin, and Tetracyclines [21]. Another study from
Turkey reported 61.8% of antibiotic use in COVID-19 patients
and it includes a combination of beta-lactams, and macrolides or
fluoroquinolones, and in patients in the ICU, piperacillin/tazobactam
was the most prescribed antibiotic [22]. A study from the USA
found that 50% of hospitalized COVID-19 patients had Mycoplasma
pneumonia co-infection which is significantly higher than other
bacterial infections [23].
The antibiotic prescription rate in Bangladesh was evaluated in
a study and found that the antibiotic prescribing rate among SARSCoV-
2 positive patients at a Bangladesh tertiary COVID-19-dedicated
hospital indicate that 100% of hospitalized patients were getting at
least one antibiotic which includes ceftriaxone (53.8%), meropenem
(40.9%), moxifloxacin (29.5%), and doxycycline (25.4%) [24].
Another study conducted in Bangladesh found that antimicrobial
drug use patterns are significantly high including cephalosporin and
macrolide. Azithromycin was the most frequently used antibiotic
with an estimation of 54% during the COVID-19 pandemic [25]. A
study from Pakistan reported 1.4% of a secondary bacterial infection
or co-infection in association with COVID-19, while antibiotics
were prescribed to 85.4% of COVID-19 patients as prophylaxis.
Antibiotics frequently prescribed in Pakistan include azithromycin
(35.6%), ceftriaxone (32.9%), and meropenem (7.6%) [26].
In a systemic review of 36 studies, 32 studies were on the use of
antibiotics in COVID-19 inpatients and 4 were on antibiotics used in
COVID-19 outpatients showing the higher use of antibiotics in both
cases [26]. A cohort study was performed in Spain describing the outcomes of bacterial co infections diagnosed in COVID-19 patients
mainly due to S. pneumoniae and S. aureus [26]. Hospital-acquired
bacterial superinfections, mostly caused by P. aeruginosa and E.
coli, were diagnosed in 4.3% of patients [25,27-29]. Similar findings
were reported in the Netherlands in COVID-19 patients with 1.2% of
bacterial co infections (75% pneumonia) [25]. An observational cohort
study performed in two hospitals in London reported that among
hospitalized COVID-19 patients, 2.7% had bacterial co infection
and most of the patients (up to 98%) received empirical antibiotic
treatment [27]. Many similar studies reported that COVID-19
patients received antibiotics at admission; while the reported rate
of bacterial infections was lower [27-31]. Another retrospective
observational study reported an outbreak of A. baumannii in
COVID-19 patients and identified carbapenem-resistant strains [32].
A nation wide cross-sectional study conducted in Japan covering
25% of all acute care hospitals in the country reported that 13.21% of
COVID-19 patients received antibiotics. Antibiotics were prescribed
more often in inpatients (16.15%) than outpatients (10.53%) and
which is significant at p < 0.001. The most frequently prescribed
antibiotic among outpatients was cefazolin, while that among
inpatients was ceftriaxone [33]. A study from Malaysia found that
the prevalence of antibiotic usage was 17.1%, with 5.5% of them
being prescribed two or more types of antibiotics. The most frequent
antibiotics prescribed were amoxicillin/clavulanic acid (37.8%),
ceftriaxone (12.3%), piperacillin/tazobactam (13.3%), azithromycin
(8.3%), and meropenem (7.0%) [34].
Post covid-19 Antibiotics Resistance:
There is emerging evidence of antibiotic resistance, particularly
for antibiotics most used to treat secondary bacterial infections in
COVID-19 patients. Overuse of these antibiotics in COVID-19
patients has contributed to developing the new, antibiotic resistant
bacterial strains against amoxicillin, azithromycin, and
cephalosporins [25,35,36]. A study published in 2021 found that over
80% of COVID-19 patients received antibiotics, and 70% of those
patients received broad-spectrum antibiotics such as cephalosporins
and fluoroquinolones [36-40]. The study also found that 70% of the
bacteria isolated from COVID-19 patients were resistant to at least
one antibiotic, and over 15% were multidrug-resistant bacteria,
such as Escherichia coli, Klebsiella pneumonia and Pseudomonas
aeruginosa. Another study published in 2021 reported that the most
identified bacteria in COVID-19 patients with secondary bacterial
infections were methicillin-resistant Staphylococcus aureus (MRSA)
and carbapenem-resistant Acinetobacter baumannii (CRAB) [41].Azithromycin and Clarithromycin were the antibiotics commonly
prescribed for COVID-19 patients, particularly those with severe
symptoms [36-40]. Many studies have shown that clarithromycin
resistance is becoming an increasing concern, particularly in
the treatment of respiratory tract infections such as pneumonia.
Clarithromycin resistance in Streptococcus pneumoniae increased
from 11% in 2011 to 17.8% in 2018 and it increases the resistance
significantly after COVID-19 pandemic. [39,40].
A study published in 2021 found that, among COVID-19 patients
in a hospital in Turkey, the most isolated bacteria were Staphylococcus
aureus and Klebsiella pneumonia. Both bacterial strains are known to
have high rates of resistance to cephalosporin antibiotics [22]. The
study highlights the importance of implementing infection control
measures and judicious antibiotic use in COVID-19 patients to
prevent the development of antibiotic-resistant bacterial infections.
Another study published in 2020 found that in a hospital in China,
patients with severe COVID-19 symptoms were more likely to develop
secondary bacterial infections with multiple antibiotic resistance,
including cephalosporins [39-40]. A report by the European Centre
for Disease Prevention and Control (ECDC) in 2020 found that the
prevalence of penicillin-resistant S. pneumoniae ranged from less
than 5% in some countries to over 50% in others [40].
Carbapenems are a class of antibiotics that are often used as a
last resort for treating serious bacterial infections, but some strains of
bacteria have developed resistance to these drugs. The most reported
carbapenem-resistant bacteria are Klebsiella pneumonia and
Acinetobacter baumannii, which can cause infections in healthcare
settings [32]. A tertiary care hospital in North India compared
the carbapenem resistance rates from August-October 2019 with
those in early 2021. Overall carbapenem resistance increased from
23% (pre-COVID) to 41% (COVID period) in Escherichia coli,
Klebsiella pneumonia, Acinetobacter baumannii, and Pseudomonas
aeruginosa [32].
There have been reports of increased antibiotic resistance to
ciprofloxacin in post-COVID-19 patients. A study published in
June 2021 found that among COVID-19 patients, there was a high
prevalence of ciprofloxacin-resistant bacteria, with 44% of the isolates
showing resistance to ciprofloxacin. Another study published in 2021
found that ciprofloxacin resistance was more common in COVID-19
patients with severe disease compared to those with mild or moderate
disease [25]. A study from Turkey confirms 8.7% of patients
were confirmed for respiratory or circulatory tract infections via
microbial culture results with Staphylococci species and Acinetobacter
baumannii, and Klebsiella pneumonia. A. baumannii, were resistant
to all antibiotics other than colistin [22].
Factors Accelerated the Emergence of Antibiotic Resistance during COVID-19 pandemic:
Bacteria can acquire antibiotic resistance through mutation,
horizontal gene transfer, efflux pumps, and other mechanisms which
are listed in Table 2 [41-45]. These mechanisms can occur in various
combinations and can lead to the emergence of antibiotic-resistant
bacterial strains. The development of resistance is a complex and
ongoing process, and it is important to continue to monitor and
develop new strategies to combat antibiotic resistance.The main factors which accelerated antibiotic resistance during
the COVID-19 pandemic include the wide use of antibiotics as
prophylaxis, prolonged and unscientific use of steroids, and overuse
and misuse of antibiotics.
Antibiotic Prophylaxis and Resistance:
Antibiotics were widely used during the COVID-19 pandemic
as prophylaxis. Antibiotic prophylaxis, which involves the use of
antibiotics to prevent infection before a medical procedure, has been
associated with the development of antibiotic resistance. The overuse
and misuse of antibiotics can contribute to the emergence of resistant
bacterial strains, as bacteria can develop genetic mutations or acquire
resistance genes through horizontal gene transfer [41]. To mitigate
the risk of antibiotic resistance associated with antibiotic prophylaxis,
it is important to use these drugs judiciously and only when necessary.
Antibiotic use should be limited to cases in which the benefits of
prophylaxis outweigh the risks, and appropriate infection prevention
and control measures should also be employed to minimize the
risk of infection. In addition, efforts to promote the development
of new antibiotics and alternative treatments for infections can
help to reduce reliance on current drugs and slow the development
of resistance. Prophylaxis refers to the use of preventive measures,
such as medications or procedures, to prevent the development of a
disease or infection. The purpose of prophylaxis is to reduce the risk
of infection or disease transmission in individuals who are at elevated
risk, particularly in situations where the risk of infection or disease
transmission is high.There are several situations where prophylaxis may be necessary,
including:
• Surgery: Antibiotic prophylaxis is often used before surgery
to prevent infections that can occur during and after the
surgery.
• Immuno compromised patients: Patients with weakened
immune systems due to medical conditions, such as HIV,
cancer, or organ transplantation, are at high risk of developing
infections, and may require prophylactic treatment.
• Exposure to infectious agents: People who have been exposed
to infectious agents, such as healthcare workers, may require
prophylaxis to prevent the development of infection.
• Chronic medical conditions: People with chronic medical
conditions, such as heart disease, may require prophylactic
treatment to prevent complications that may arise due to
their condition.
Overall, the goal of prophylaxis is to prevent the development
of infections or diseases in high-risk individuals, and it is often an
important part of disease management and infection control. The
decision to use prophylaxis is based on individual risk factors, the
severity of the disease, and the potential benefits and risks of the
prophylactic treatment.
Antibiotic-resistant genes can be transferred from normal flora
to pathogens which can lead to the development of antibiotic resistant
strains. Horizontal gene transfer is a mechanism by which
bacteria can transfer resistant genes from one to another bacteria through transformation, transduction, and conjugation, leading to
resistance against multiple antibiotics. In contrast, bacteria can also
acquire resistance to several antibiotics through the accumulation of
mutations over time, which happens due to natural selection [41-45].
Steroid and Antibiotic Resistance:
Steroids can have both beneficial and detrimental effects on
the immune system, and their use has been associated with the
development of antibiotic resistance in some cases. One of the
ways in which steroids can contribute to antibiotic resistance is by
suppressing the immune response and leads to bacterial infections.
When the immune system is weakened, bacteria may be better able
to replicate and evade the body’s natural defenses, making infections
more difficult to treat with antibiotics. In addition, steroids can also
have direct effects on bacterial cells that can promote resistance. For
example, some studies have suggested that steroids may increase the
expression of genes that are involved in antibiotic resistance in certain
bacterial species. Furthermore, because steroids are often used in
combination with antibiotics to treat certain infections, the potential
for resistance to develop may be increased. This is particularly true in
cases where the antibiotic and steroid are not carefully selected and
prescribed based on the specific infection and patient characteristics
[46-50].The use of steroids can contribute to antibiotic resistance, it is
important to note that these drugs can also be very beneficial in certain
circumstances. For example, they may be used to reduce inflammation
and improve respiratory function in patients with severe respiratory
illnesses, such as COVID-19. In some cases, bacterial infections can
cause significant inflammation, and treatment with both antibiotics
and steroids can be beneficial. For example, in severe cases of
community-acquired pneumonia, treatment with both antibiotics
and steroids may be necessary to reduce inflammation and combat
the infection. In bacterial meningitis, steroids are often given in
combination with antibiotics to reduce inflammation of the meninges
and improve outcomes. While the combination of antibiotics and
steroids can be effective in treating certain conditions, there are also
potential risks and side effects associated with their use. Long-term
use of steroids can suppress the immune system, and it can be leading
to an opportunistic bacterial or fungal infection. Steroids may be
given in combination with antibiotics in the treatment of severe or
complicated cases of sinusitis, as they can reduce inflammation and
improve outcomes [46-50].
Steroids have been shown to alter gene expression in bacteria,
potentially leading to changes in antibiotic resistance. For example, a study found that dexamethasone, a type of steroid, increased
the expression of genes associated with resistance to the antibiotic
tetracycline in E. coli bacteria. Efflux pumps are transporters that can
pump antibiotics out of bacterial cells, reducing their effectiveness
[47-49]. Some studies suggest that steroids can induce the expression
of efflux pumps, making it more difficult for antibiotics to kill the
bacteria. Some steroids, such as prednisolone, have been shown to
interfere with the mechanisms by which antibiotics kill bacteria,
making them less effective [49]. Overuse of Dexamethasone, a type
of glucocorticoid steroid could be one of the main reasons for post-
COVID-19 bacterial pneumonia and fungal infections [48].
Overuse and misuse of Antibiotics:
The overuse and misuse of antibiotics are one of the main factors
contributing to the development of antibiotic resistance. When
antibiotics are used inappropriately, such as for viral infections or for
conditions that do not require antibiotics, this can contribute to the
development of resistance [41]. In addition, antibiotics can disrupt
the normal bacterial flora in the body, leading to an overgrowth
of antibiotic-resistant bacteria or other pathogens. Therefore, it is
important to use antibiotics judiciously and only when they are
necessary to treat a bacterial infection.Antibiotics target specific structures or processes unique to
bacteria, such as cell walls or protein synthesis. Viruses, on the
other hand, do not have these structures, and they rely on host
cells to replicate. Therefore, antibiotics are not effective in treating
viral infections such as the common cold, influenza, or COVID-19.
However, in some cases, individuals with viral infections may also
develop bacterial infections, either as a secondary infection or as a
co-infection. In these cases, antibiotics may be necessary to treat the
bacterial infection. The widespread use of antibiotics in humans and
livestock has contributed to the development of antibiotic resistance
in both animals and humans.
The incomplete course of antibiotic treatment can contribute to
the development of antibiotic resistance in a few different ways. When
antibiotics are not taken for the full prescribed duration, they may not
eliminate the target bacteria, allowing some to survive and potentially
develop resistance to the antibiotic. These surviving bacteria can then
spread and cause recurrent or persistent infections that may be more
difficult to treat [41].
Long-term antibiotic use can contribute to the development of
antibiotic resistance in several ways. When antibiotics are used over
a prolonged period, they can promote the survival and proliferation of bacteria that have acquired resistance mechanisms, leading to the
emergence of resistant strains. Long-term antibiotic use can also
disrupt the normal balance of microbial communities in the body,
including the gut microbiota. This can lead to the overgrowth of
opportunistic pathogens and colonization by antibiotic-resistant
bacteria, which can contribute to the development of antibiotic resistant
infections. Evidence suggests that long-term antibiotic
use can lead to the accumulation of resistance genes in microbial
populations, which can then be transferred to other bacterial species,
including potential pathogens [41-45].
MIC Studies on Bacterial isolates from COVID-19 Patients:
A study published in the Journal of Global Antimicrobial
Resistance in June 2021 evaluated the susceptibility patterns of
bacteria isolated from patients with COVID-19 in a hospital in India.
The study found that the most common bacterial pathogens were
Klebsiella pneumonia, Pseudomonas aeruginosa, and Acinetobacter
baumannii and that they showed high levels of resistance to several
antibiotics, including carbapenems, 3rd generation cephalosporins,
and fluoroquinolones [32,51]. The study highlights the importance
of antibiotic stewardship programs to prevent the emergence of
antibiotic resistance.Another study published in the Journal of Medical Microbiology
in July 2021 evaluated the MIC values of antibiotics against bacterial
pathogens isolated from COVID-19 patients in a hospital in Poland.
The study found that the most common pathogens were Klebsiella pneumonia and Staphylococcus aureus and that they exhibited high
levels of resistance to several antibiotics, including carbapenems and
fluoroquinolones [44]. The study also found that the MIC values for
several antibiotics increased during the pandemic, highlighting the
need for surveillance, and monitoring of antibiotic resistance during
this time. A study published in the journal Lancet Infectious Diseases
in January 2022 reported the emergence of high-level resistance to
carbapenems in Enterobacterales bacteria in a hospital in China [18].
Another study published in the journal Clinical Infectious Diseases
in March 2022 found that prolonged courses of antibiotics were
associated with increased rates of antibiotic resistance in patients
with bloodstream infections caused by Enterobacterales [19].
A comparative study on MIC (minimum inhibitory concentration)
values for antibiotics in the pre-COVID-19 and post-COVID-19
periods published in the Journal of Global Antimicrobial Resistance
in August 2021 evaluated the antibiotic susceptibility patterns of bacterial isolates from patients with COVID-19 in Pakistan and
compared them to a historical control group of bacterial isolates
obtained from patients without COVID-19 in the same hospital. The
study found that the isolates from patients with COVID-19 had higher
rates of resistance to multiple antibiotics, including azithromycin,
ceftriaxone, and meropenem, compared to the control group [39].
Another study published in the Journal of Medical Microbiology
in December 2021 evaluated the antibiotic susceptibility patterns
of bacterial isolates from patients with COVID-19 in the United
Kingdom and compared them to isolates obtained from patients
without COVID-19 at the same time. The study found that the
isolates from patients with COVID-19 had similar rates of antibiotic
resistance to the control group. Still, there were differences in the
distribution of resistance patterns, with higher rates of resistance
to certain antibiotics such as ceftriaxone and azithromycin in the
COVID-19 group [52]. Overall, these studies suggest that there may be
differences in the antibiotic susceptibility patterns of bacterial isolates
obtained from patients with COVID-19 compared to historical
control groups or patients without COVID-19. However, the specific
patterns of resistance may vary depending on the geographic region,
patient population, and other factors. There are various automated
MIC analyzers available that provide most of the results within 12-
18 hours, and a preliminary results can obtained after 4 hours of
incoculation (Figure 3).
Figure 3: An automated MIC analyzer (Vitek 2, bioMerieux), used for the invitro
studies of antibiotics.
Antibiotic resistance is a growing concern in modern medicine,
and the treatment of patients with antibiotic-resistant strains requires
a careful and individualized approach. The choice of modality will
depend on the severity of the infection, the patient’s overall health,
and the specific characteristics of the antibiotic-resistant strain. In
general, the first step in treating a patient with an antibiotic-resistant
strain is to obtain a culture and sensitivity or MIC test to determine
the specific type of bacteria causing the infection and the most
effective antibiotics to treat it. Once this information is available, the
healthcare provider can decide on the best modality for treatment.
Possible modalities for patients with antibiotic-resistant strains
may include:
• Alternative antibiotics: MIC will provide the best option
of the alternate administration of antibiotics available that
are effective against the resistant strain. This may involve
using higher doses of the antibiotic or combining multiple
antibiotics.
• Antimicrobial stewardship: This involves using antibiotics
in a more targeted and responsible manner to prevent the
development of resistance. This may include limiting the
use of antibiotics to only when they are necessary, using
the appropriate dose and duration of treatment, and using
narrow-spectrum antibiotics when possible.
• Combination therapy: This involves using two or more
antibiotics together to improve their effectiveness. This
approach may be particularly useful for treating infections
caused by multidrug-resistant bacteria.
• Non-antibiotic therapies: This includes non-antibiotic
therapies used to treat infections caused by antibiotic resistant
strains. These may include phage therapy, which uses viruses to target and kill specific bacteria, or immunotherapy,
which involves using the body’s immune system to fight the
infection.
• Mode of administration: In cases of antibiotic-resistant
infections, intravenous (IV) administration of antibiotics
may be more effective than oral administration. This is
because IV antibiotics can achieve higher concentrations
in the bloodstream and target the site of an infection more
directly than oral antibiotics. IV administration allows the
antibiotics to bypass the gastrointestinal tract, where they
may be affected by factors such as pH, enzymes, and food.
This can be particularly important in cases where the patient’s
gastrointestinal tract is compromised, such as in patients with
severe infections, nausea, or vomiting.
• Monitoring marker tests: The response to treatment should
evaluate with total WBC count, C-Reactive Protein (CRP):
and Procalcitonin (PCT).
The choice of modality will depend on the specific circumstances
of the patient’s infection and the characteristics of the antibioticresistant
strain. Preventing hospital-associated infections and
antibiotic resistance in healthcare facilities requires strict adherence
to infection prevention and control practices and ongoing monitoring
and surveillance of antibiotic use and resistance. Healthcare facilities
must also have robust antibiotic stewardship programs to ensure that
antibiotics are used judiciously and appropriately to minimize the
risk of antibiotic resistance.
Conclusion
Post-COVID-19 studies recorded bacterial strains resistant to
beta-lactams including amoxicillin, cephalosporins, and carbapenem.
The wide use of macrolides such as azithromycin, and clarithromycin
developed resistant strains in certain geographical areas. Bacterial
strains resistant to fluoroquinolones such as Ciprofloxacin and
Levofloxacin were developed in patients with co-infections. The
overuse or misuse of these antibiotics in COVID-19 patients has
contributed to the development of new, antibiotic-resistant bacterial
strains including Klebsiella pneumonia, Acinetobacter baumannii,
Escherichia coli, and Pseudomonas aeruginosa which showed multiple
antibiotic resistance. Overuse of steroids was another reason for post-
COVID-19 bacterial pneumonia and its resistance to antibiotics.
Acknowledgment
The authors would like to thank bioMerieux, France, and Al
Hayat Pharmaceuticals, UAE for promoting the in-vitro MIC studies
of antibiotics.